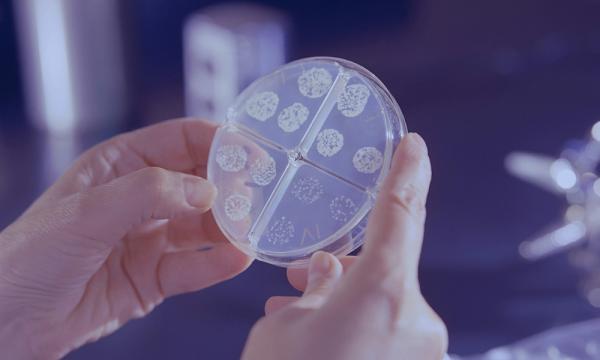
Seorang murid di Pontian disahkan dijangkiti tibi

Seorang murid di Pontian disahkan dijangkiti tibi
Tindakan segera telah diambil untuk mengenal pasti semua kontak rapat agar menjalani saringan kesihatan, kata Exco Pendidikan Aznan Tamin.
Tindakan segera telah diambil untuk mengenal pasti semua kontak rapat agar menjalani saringan kesihatan, kata Exco Pendidikan Aznan Tamin.

TEMERLOH - Satu rangka manusia tanpa identiti ditemukan di kawasan parit dan belukar berhampiran Flat Damai Taha, Mentakab.Ketua Polis Daerah Temerloh, Asisten Komisioner Mohd Nasyim Bahron berkata, pihaknya menerima maklumat awam berhubung penemuan itu kira-kira jam 12 tengah hari pada Ahad.Susulan penemuan itu beliau berkata, sepasukan pegawai dan anggota polis bersama Bahagian Forensik Ibu Pejabat Polis Kontinjen (IPK) Pahang telah menjalankan pemeriksaan awal di lokasi kejadian."Hasil siasatan awal menemukan rangka manusia yang dipercayai seorang wanita berdasarkan pakaian ditemui."Rangka manusia itu dibawa ke Jabatan Forensik Hospital Sultan Haji Ahmad Shah (HosHAS), Temerloh bagi tujuan proses bedah siasat yang akan dijalankan pada 10 Februari ini," katanya menerusi kenyataan pada Isnin.Mohd Nasyim berkata, siasatan lanjut masih dijalankan dan kertas siasatan di bawah Mati Mengejut (SDR) telah dibuka sementara menunggu laporan penuh daripada pihak Forensik.Sehubungan itu, Mohd Nasyim berkata orang ramai yang mempunyai maklumat berkaitan kejadian diminta menghubungi Pegawai Penyiasat, Inspektor Mohd Razzi Ismail di talian 017-231 4.

LONDON – Seorang calon pilihan raya kecil di Britain mengundang kritikan orang ramai kerana mencadangkan dasar cukai tambahan kepada lelaki dan wanita yang tidak mempunyai anak, lapor akhbar Metro UK semalam. Matt Goodwin yang merupakan calon pilihan raya kecil Gorton dan Denton yang akan datang, mencadangkan cara untuk menangani penurunan kadar kelahiran di Britain dalam ... Read more The post Calon pilihan raya cadang cukai tinggi untuk rakyat tiada anak appeared first on Kosmo Digital .

This is expected to raise the state-owned company’s crude entitlement, thereby enhancing revenue streams and supply reliability for Sabah.

DUBAI: Pihak Berkuasa Pendidikan Swasta Sharjah (SPEA) memberikan kebenaran kepada sekolah-sekolah swasta di negara tersebut untuk menetapkan jadual waktu Ramadan mereka sendiri. Namun dengan syarat tempoh sesi persekolahan tidak melebihi enam jam sehari. Menurut pekeliling rasmi yang dikeluarkan, pihak berkuasa menyatakan sekolah dibenarkan menentukan waktu mula dan tamat sesi bagi pelajar serta kakitangan akademik sepanjang ... Read more The post Sesi persekolahan di Dubai tidak boleh melebihi enam jam sepanjang Ramadan appeared first on Utusan Malaysia .

Pejabat Kesihatan Daerah Pontian ambil tindakan segera dengan mengenal pasti semua kontak rapat dan memaklumkan mereka untuk hadir ke Klinik Kesihatan.

CORTINA – Legenda ski Amerika Syarikat (AS), Lindsey Vonn patah kaki kiri selepas terlibat dalam kemalangan ngeri pada acara downhill wanita di Sukan Olimpik Musim Sejuk 2026 di Milan-Cortina, Itali awal pagi tadi. Insiden tersebut menjadi penamat tragis kepada karier luar biasa pelumba berusia 41 tahun itu yang sebelum ini nekad untuk bertanding walaupun baru ... Read more The post Penamat tragis legenda ski dunia appeared first on Kosmo Digital .

OP TARING DELTA | Briged Tengah Pasukan Gerakan Am (PGA) menumpaskan satu sindiket penyeludupan migran selepas menahan 22 warga asing dalam gerakan semalam. Tangkapan itu membabitkan 20 lelaki dan dua wanita dewasa warga Indonesia, termasuk empat daripada mereka dipercayai

A Chinese foreign ministry spokesman on Monday urged Japan to retract Sanae Takaichi’s remarks on Taiwan and warned of consequences for any rash actions.

When it comes to public transport systems, not all plans will come to fruition. As it turns out, Putrajaya Corporation (PPj) will not proceed with the proposed Automated Rapid Transit (ART) trackless tram system. This is due to the high projected costs, which would be beyond the capacity of PPj as a local authority. Deputy […] The post Putrajaya Drops Proposed Automated Rapid Transit System Over High Costs appeared first on Lowyat.NET .

PORT DICKSON: Kehadiran udang kara yang dikesan di sebuah parit kecil Kampung Si Rusa Dalam di sini, sekali gus menimbulkan kebimbangan terhadap kelestarian ekosistem ikan air tawar tempatan. Seorang pemancing, Muhamad Tarmize Mohd Nor, 38, berkata, dia mula mendapati perubahan ketara pada hasil tangkapan selepas mula memancing di parit berkenaan sejak pertengahan tahun lalu. “Parit ... Read more The post Udang kara jejas tangkapan kaki pancing ikan appeared first on Utusan Malaysia .

IPOH:The Perak Minerals and Geoscience Department (JMG) has not received any complaints about the mysterious loud noise heard in several areas here and surrounding districts. Read full story

IPOH:The Perak Minerals and Geoscience Department (JMG) has not received any complaints about the mysterious loud noise heard in several areas here and surrounding districts. Read full story

KUALA LUMPUR, Feb 9 — A new National Cost-of-Living Action Plan, scheduled for launch in the second quarter of thi...

MANILA, Feb 9 — Members of the Philippine clergy filed an impeachment complaint Monday against Sara Duterte, the t...

KUALA LUMPUR, Feb 9 (Bernama) -- Micro, small and medium enterprises (MSMEs) can now apply for the 2026 programmes under the 13th Malaysia Plan (13MP) implemented by SME Corporation Malaysia (SME Corp).